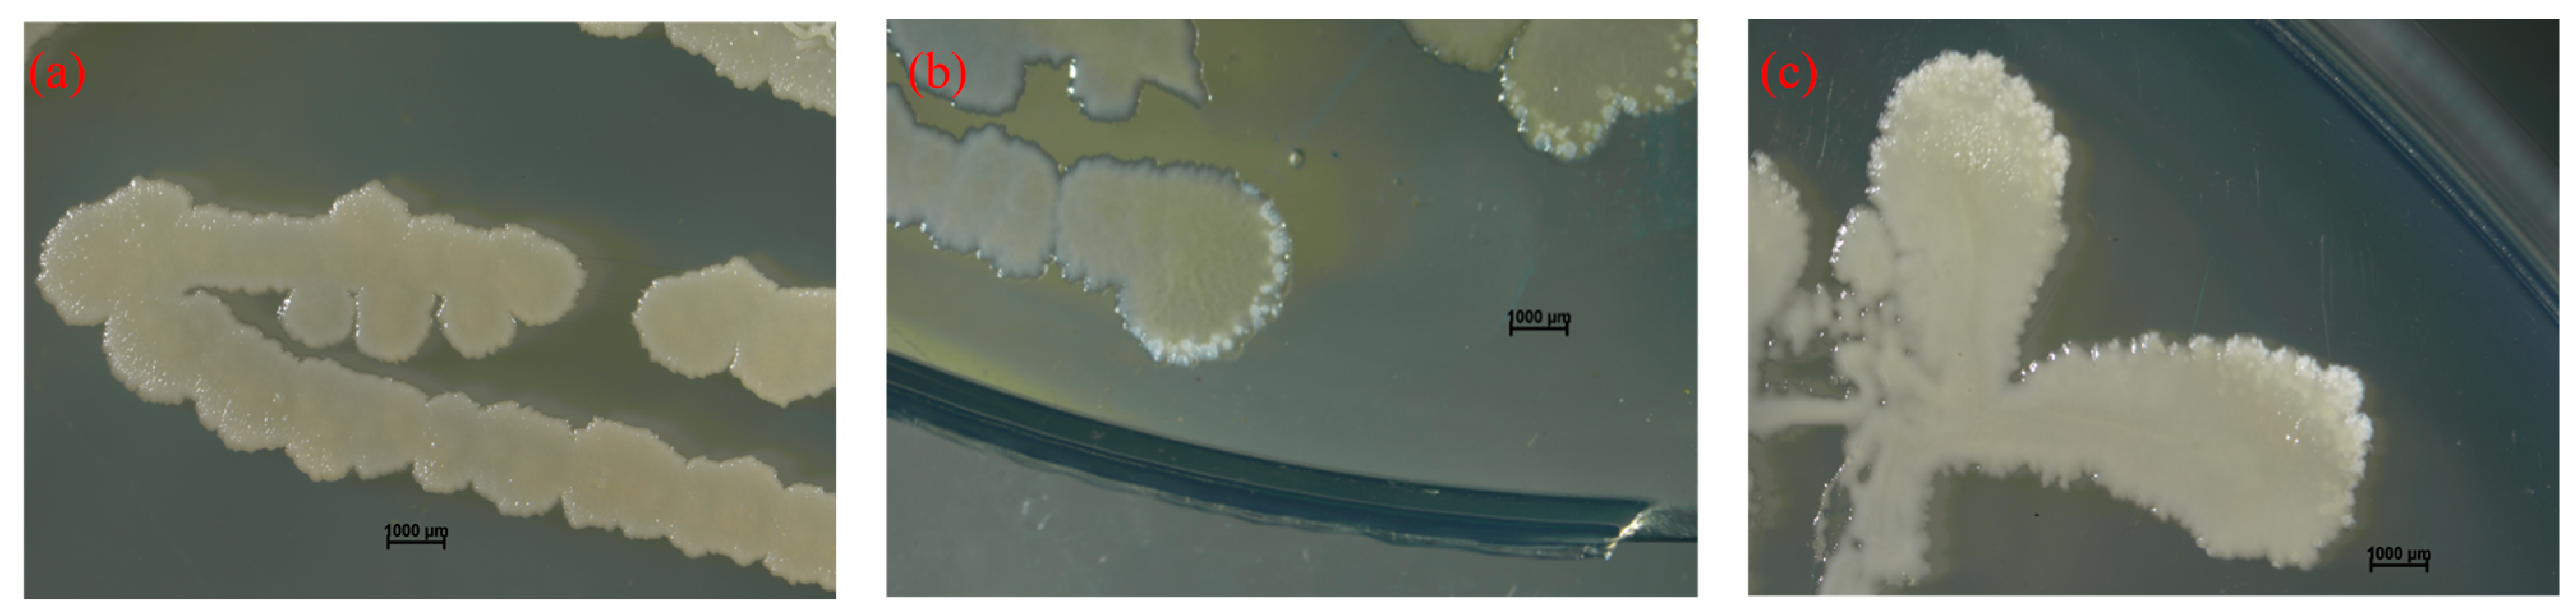

Heterologous Expression and Functional Verification of Extracellular Carbonic Anhydrases in Bacillus safensis yw6 from Mariana Trench
Abstract
1. Introduction
2. Results
2.1. Bioinformatic Analysis
2.2. The ca Gene Extraction and Detection
2.3. The ca Genes Cloning and Expression
2.4. Expression and Purification of Extracellular CA Proteins
2.5. Determination of Extracellular CAs Activity of Engineering Bacteria
3. Discussion
4. Materials and Methods
4.1. The Origin of the B. safensis yw6
4.2. Bioinformatic Analysis
4.3. The ca Gene Extraction and Detection
4.4. The ca Genes Cloning and Expression
4.5. Expression and Purification of Extracellular CA Proteins
4.6. Determination of Extracellular CAs Activity of Engineering Bacteria
5. Conclusions
Author Contributions
Funding
Institutional Review Board Statement
Informed Consent Statement
Data Availability Statement
Conflicts of Interest
References
- Mwenketishi, G.T.; Benkreira, H.; Rahmanian, N. A Comprehensive Review on Carbon Dioxide Sequestration Methods. Energies 2023, 16, 7971. [Google Scholar] [CrossRef]
- Jiang, P.; Xiao, L.Q.; Wan, X.; Yu, T.; Liu, Y.F.; Liu, M.X. Research progress on microbial carbon sequestration in soil: A review. Eurasian Soil Sci. 2022, 55, 1395–1404. [Google Scholar] [CrossRef]
- Garcia-Lopez, E.; Ruiz-Blas, F.; Sanchez-Casanova, S.; Peña Perez, S.; Martin-Cerezo, M.L.; Cid, C. Microbial communities in volcanic glacier ecosystems. Front. Microbiol. 2022, 13, 825632–825644. [Google Scholar] [CrossRef] [PubMed]
- Yaashikaa, P.R.; Saravanan, A.; Kumar, P.S.; Thamarai, P.; Rangasamy, G. Role of microbial carbon capture cells in carbon sequestration and energy generation during wastewater treatment: A sustainable solution for cleaner environment. Int. J. Hydrogen Energy 2024, 52, 799–820. [Google Scholar] [CrossRef]
- Gruber, N.; Bakker, D.C.; DeVries, T.; Gregor, L.; Hauck, J.; Landschützer, P.; McKinley, G.A.; Müller, J.D. Trends and variability in the ocean carbon sink. Nat. Rev. Earth Environ. 2023, 4, 119–134. [Google Scholar] [CrossRef]
- Horikoshi, K. Barophiles: Deep-sea microorganisms adapted to an extreme environment. Curr. Opin. Microbiol. 1999, 1, 291–295. [Google Scholar] [CrossRef] [PubMed]
- Gao, B.; Jin, M.; Li, L.; Qu, W.; Zeng, R. Genome sequencing reveals the complex polysaccharide-degrading ability of novel deep-sea bacterium Flammeovirga pacifica WPAGA1. Front. Microbiol. 2017, 8, 600. [Google Scholar] [CrossRef]
- Qin, W.; Wang, C.Y.; Ma, Y.X.; Shen, M.J.; Li, J.; Jiao, K.; Tay, F.R.; Niu, L.N. Microbe-mediated extracellular and intracellular mineralization: Environmental, industrial, and biotechnological applications. Adv. Mater. 2020, 32, 1907833. [Google Scholar] [CrossRef] [PubMed]
- Yue, X.L.; Xu, L.; Cui, L.; Fu, G.Y.; Xu, X.W. Metagenome-based analysis of carbon-fixing microorganisms and their carbon-fixing pathways in deep-sea sediments of the southwestern Indian Ocean. Mar. Genom. 2023, 70, 101045. [Google Scholar] [CrossRef] [PubMed]
- Zheng, T.; Qian, C. Influencing factors and formation mechanism of CaCO3 precipitation induced by microbial carbonic anhydrase. Process Biochem. 2020, 91, 271–281. [Google Scholar] [CrossRef]
- Supuran, C.T.; Capasso, C. An Overview of the Bacterial Carbonic Anhydrases. Metabolites 2017, 7, 56–74. [Google Scholar] [CrossRef] [PubMed]
- Lindskog, S.; Engberg, P.; Forsman, C.E.C.I.L.I.A.; Ibrahim, S.A.; Jonsson, B.H.; Simonsson, I.; Tibell, L.E.N.A. Kinetics and Mechanism of Carbonic Anhydrase Isoenzymes. Ann. N. Y. Acad. Sci. 1984, 429, 61–75. [Google Scholar] [CrossRef] [PubMed]
- Smith, K.S.; Jakubzick, C.; Whittam, T.S.; Ferry, J.G. Carbonic anhydrase is an ancient enzyme widespread in prokaryotes. Proc. Natl. Acad. Sci. USA 1999, 96, 15184–15189. [Google Scholar] [CrossRef] [PubMed]
- Sun, J.; Zhao, C.; Zhao, S.; Dai, W.; Liu, J.; Zhang, J.; Xu, J.; He, P. Diversity of CO2 Concentrating Mechanisms in Macroalgae Photosynthesis: A Case Study of Ulva sp. J. Mar. Sci. Eng. 2023, 11, 1911–1928. [Google Scholar] [CrossRef]
- Sharker, M.R.; Kim, S.C.; Hossen, S.; Sumi, K.R.; Choi, S.K.; Choi, K.S.; Kho, K.H. Carbonic anhydrase in Pacific Abalone Haliotis discus hannai: Characterization, expression, and role in Biomineralization. Front. Mol. Biosci. 2021, 8, 655115–655126. [Google Scholar] [CrossRef]
- Anindita, H.; Meera, Y. Biomineralization of carbon dioxide by carbonic anhydrase. Biocatal. Agric. Biotechnol. 2023, 51, 102755. [Google Scholar]
- Caulfield, B.; Abraham, J.; Christodoulatos, C.; Prigiobbe, V. Enhanced precipitation of magnesium carbonates using carbonic anhydrase. Nanoscale 2022, 14, 13570–13579. [Google Scholar] [CrossRef]
- Yuan, Y.; Wang, F.; Li, H.; Su, S.; Gao, H.; Han, X.; Ren, S. Potential application of the immobilization of carbonic anhydrase based on metal organic framework supports. Process Biochem. 2022, 122, 214–223. [Google Scholar] [CrossRef]
- Molina-Fernández, C.; Luis, P. Immobilization of carbonic anhydrase for CO2 capture and its industrial implementation: A review. J. CO2 Util. 2021, 47, 101475. [Google Scholar] [CrossRef]
- Baidya, P.; Dahal, B.K.; Pandit, A.; Joshi, D.R. Bacteria-induced calcite precipitation for engineering and environmental applications. Adv. Mater. Sci. Eng. 2023, 2023, 2613209. [Google Scholar] [CrossRef]
- Mangrulkar, P.A.; Chilkalwar, A.A.; Kotkondawar, A.V.; Manwar, N.R.; Antony, P.S.; Hippargi, G.; Labhsetwar, N.; Trachtenberg, M.C.; Rayalu, S.S. Plasmonic nanostructured Zn/ZnO composite enhances carbonic anhydrase driven photocatalytic hydrogen generation. J. CO2 Util. 2016, 17, 207–212. [Google Scholar] [CrossRef]
- Supuran, C.T. Structure and function of carbonic anhydrases. Biochem. J. 2016, 473, 2023–2032. [Google Scholar] [CrossRef] [PubMed]
- Whyte, M.P. Carbonic anhydrase II deficiency. Bone 2023, 294, 52–63. [Google Scholar] [CrossRef]
- Mboge, M.Y.; Mahon, B.P.; McKenna, R.; Frost, S.C. Carbonic anhydrases: Role in pH control and cancer. Metabolites 2018, 8, 19–49. [Google Scholar] [CrossRef]
- Nölke, G.; Barsoum, M.; Houdelet, M.; Arcalís, E.; Kreuzaler, F.; Fischer, R.; Schillberg, S. The integration of algal carbon concentration mechanism components into tobacco chloroplasts increases photosynthetic efficiency and biomass. Biotechnol. J. 2019, 14, 1800170. [Google Scholar] [CrossRef] [PubMed]
- Hu, Z.; Ma, Q.; Foyer, C.H.; Lei, C.; Choi, H.W.; Zheng, C.; Li, J.; Zuo, J.; Mao, Z.; Mei, Y.; et al. High CO2-and pathogen-driven expression of the carbonic anhydrase βCA3 confers basal immunity in tomato. N. Phytol. 2020, 229, 2827–2843. [Google Scholar] [CrossRef]
- Zolfaghari Emameh, R.; Barker, H.; Hytönen, V.P.; Tolvanen, M.E.; Parkkila, S. Beta carbonic anhydrases: Novel targets for pesticides and anti-parasitic agents in agriculture and livestock husbandry. Parasites Vectors 2014, 7, 403. [Google Scholar] [CrossRef] [PubMed]
- Jiangfeng, N.; Maolin, L.; Rui, C.; Wei, Y.; Qiushi, C.; Hongqiang, J. Effect of grinding method on particle morphology and flotation behavior of calcite. Conserv. Util. Miner. Resour. 2020, 40, 51–55. [Google Scholar]
- Zhang, F.; Liu, J.; Li, Q.; Zou, L.; Zhang, Y. The research of typical microbial functional group reveals a new oceanic carbon sequestration mechanism−A case of innovative method promoting scientific discovery. Sci. China Earth Sci. 2016, 59, 456–463. [Google Scholar] [CrossRef]
- Buesseler, K.O.; Boyd, P.W.; Black, E.E.; Siegel, D.A. Metrics that matter for assessing the ocean biological carbon pump. Proc. Natl. Acad. Sci. USA 2020, 117, 9679–9687. [Google Scholar] [CrossRef]
- Neukermans, G.; Bach, L.T.; Butterley, A.; Sun, Q.; Claustre, H.; Fournier, G.R. Quantitative and mechanistic understanding of the open ocean carbonate pump-perspectives for remote sensing and autonomous in situ observation. Earth-Sci. Rev. 2023, 239, 104359–160804. [Google Scholar] [CrossRef]
- Liu, S.S.; Song, J.M.; Li, X.G.; Yuan, H.M.; Duan, L.Q.; Li, S.C.; Wang, Z.B.; Ma, J. Enhancing CO2 storage and marine carbon sink based on seawater mineral carbonation. Mar. Pollut. Bull. 2024, 206, 116685. [Google Scholar] [CrossRef] [PubMed]
- Sumi, K.R.; Nou, I.-S.; Kho, K.H. Identification and expression of a novel carbonic anhydrase isozyme in the pufferfish Takifugu vermicularis. Gene 2016, 588, 173–179. [Google Scholar] [CrossRef] [PubMed]
- Mustaffa NI, H.; Latif, M.T.; Wurl, O. The Role of Extracellular Carbonic Anhydrase in Biogeochemical Cycling: Recent Advances and Climate Change Responses. Int. J. Mol. Sci. 2021, 22, 7413–7426. [Google Scholar] [CrossRef] [PubMed]
- Kajla, S.; Kumari, R.; Nagi, G.K. Microbial CO2 fixation and biotechnology in reducing industrial CO2 emissions. Arch. Microbiol. 2022, 204, 149. [Google Scholar] [CrossRef] [PubMed]
- Singh, S.; Lomelino, C.L.; Mboge, M.Y.; Frost, S.C.; McKenna, R. Cancer Drug Development of Carbonic Anhydrase Inhibitors beyond the Active Site. Molecules 2018, 23, 1045. [Google Scholar] [CrossRef]
- Vincent, J.; Colin, B.; Lanneluc, I.; Sabot, R.; Sopéna, V.; Turcry, P.; Mahieux, P.Y.; Refait, P.; Jeannin, M.; Sablé, S. New biocalcifying marine bacterial strains isolated from calcareous deposits and immediate surroundings. Microorganisms 2021, 10, 76–97. [Google Scholar] [CrossRef] [PubMed]

| β-CA1 | β-CA2 | γ-CA | ||||
|---|---|---|---|---|---|---|
| Amino Acid | Number | Percentage | Number | Percentage | Number | Percentage |
| Ala (A) | 7 | 3.4% | 14 | 7.1% | 10 | 5.2% |
| Arg (R) | 6 | 3.0% | 5 | 2.5% | 11 | 5.8% |
| Asn (N) | 7 | 3.4% | 5 | 2.5% | 5 | 2.6% |
| Asp (D) | 13 | 6.4% | 10 | 5.1% | 10 | 5.2% |
| Cys (C) | 2 | 1.0% | 4 | 2.0% | 1 | 0.5% |
| Gln (Q) | 5 | 2.5% | 6 | 3.0% | 9 | 4.7% |
| Glu (E) | 17 | 8.4% | 15 | 7.6% | 11 | 5.8% |
| Gly (G) | 12 | 5.9% | 17 | 8.6% | 18 | 9.4% |
| His (H) | 5 | 2.5% | 8 | 4.0% | 6 | 3.1% |
| Ile (I) | 14 | 6.9% | 12 | 6.1% | 19 | 9.9% |
| Leu (L) | 21 | 10.3% | 23 | 11.6% | 15 | 7.9% |
| Lys (K) | 22 | 10.8% | 19 | 9.6% | 10 | 5.2% |
| Met (M) | 7 | 3.4% | 7 | 3.5% | 3 | 1.6% |
| Phe (F) | 7 | 3.4% | 4 | 2.0% | 5 | 2.6% |
| Pro (P) | 8 | 3.9% | 9 | 4.5% | 9 | 4.7% |
| Ser (S) | 15 | 7.4% | 11 | 5.6% | 15 | 7.9% |
| Thr (T) | 6 | 3.0% | 6 | 3.0% | 9 | 4.7% |
| Trp (W) | 1 | 0.5% | 1 | 0.5% | 1 | 0.5% |
| Tyr (Y) | 7 | 3.4% | 4 | 2.0% | 6 | 3.1% |
| Val (V) | 21 | 10.3% | 18 | 9.1% | 18 | 9.4% |
| Type | Concentration (mg/mL) | Enzyme Activity/U | Vitality Contest (U/mg) |
|---|---|---|---|
| β-CA1 | 4.724 | 0.077 | 0.326 |
| β-CA2 | 4.303 | 0.138 | 0.641 |
| γ-CA | 5.647 | 0.121 | 0.426 |
| Purified β-CA1 | 0.85 | 0.026 | 0.306 |
| Purified β-CA2 | 1.98 | 0.081 | 0.409 |
| Purified γ-CA | 0.83 | 0.026 | 0.313 |
| Name | Primer Nucleic Acid Sequence |
|---|---|
| β-ca1 forward primer | GAAATTTCTTACATTGTGCTATATTTAT |
| β-ca1 reverse primer | TTACTTTTCTTCATATCCGTTGACAA |
| β-ca2 forward primer | ATGGGAGATGGCAAAATGGGAT |
| β-ca2 reverse primer | TTAGGTATACTGCGGGTCAATC |
| γ-ca forward primer | ATGCCAAGTCCACAAAGTAAACAC |
| γ-ca reverse primer | TTAACGAGATAAAAGGGAACGATAG |
Disclaimer/Publisher’s Note: The statements, opinions and data contained in all publications are solely those of the individual author(s) and contributor(s) and not of MDPI and/or the editor(s). MDPI and/or the editor(s) disclaim responsibility for any injury to people or property resulting from any ideas, methods, instructions or products referred to in the content. |
© 2024 by the authors. Licensee MDPI, Basel, Switzerland. This article is an open access article distributed under the terms and conditions of the Creative Commons Attribution (CC BY) license (https://creativecommons.org/licenses/by/4.0/).
Share and Cite
Wang, X.; Wang, P.; Zhao, H.; He, Y.; Qu, C.; Miao, J. Heterologous Expression and Functional Verification of Extracellular Carbonic Anhydrases in Bacillus safensis yw6 from Mariana Trench. Molecules 2024, 29, 5911. https://doi.org/10.3390/molecules29245911
Wang X, Wang P, Zhao H, He Y, Qu C, Miao J. Heterologous Expression and Functional Verification of Extracellular Carbonic Anhydrases in Bacillus safensis yw6 from Mariana Trench. Molecules. 2024; 29(24):5911. https://doi.org/10.3390/molecules29245911
Chicago/Turabian StyleWang, Xinyu, Pengna Wang, Hancheng Zhao, Yingying He, Changfeng Qu, and Jinlai Miao. 2024. "Heterologous Expression and Functional Verification of Extracellular Carbonic Anhydrases in Bacillus safensis yw6 from Mariana Trench" Molecules 29, no. 24: 5911. https://doi.org/10.3390/molecules29245911
APA StyleWang, X., Wang, P., Zhao, H., He, Y., Qu, C., & Miao, J. (2024). Heterologous Expression and Functional Verification of Extracellular Carbonic Anhydrases in Bacillus safensis yw6 from Mariana Trench. Molecules, 29(24), 5911. https://doi.org/10.3390/molecules29245911

